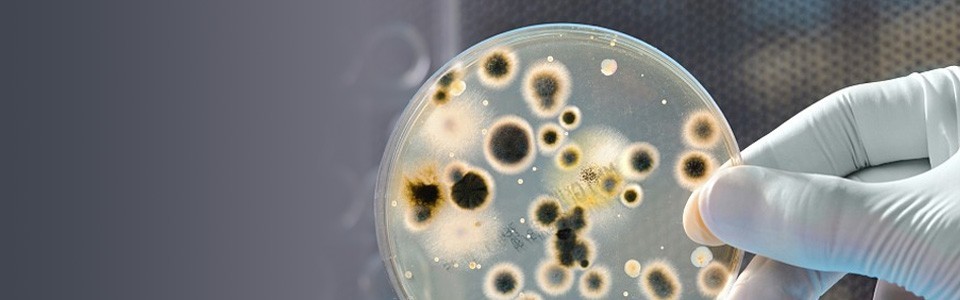
Gloved hand holding Petri dish with bacteria growing

$300K grant awarded to study airborne MRSA in health care settings
Work of UC researchers featured on insurance industry site
The Ohio Bureau of Workers’ Compensation has awarded a $300,000 grant to the University of Cincinnati to study airborne MRSA to better protect health care workers.
Most infections of MRSA, methicillin-resistant Staphylococcus aureus, occur in people who have been in hospitals, making it an especially strong risk for those working in health care settings.
Businessinsurance.com reported that researchers will be studying if MRSA, a type of staph bacteria, is present in the air in hospitals and the airborne transmission rate.
Experts say while MRSA has traditionally been transmitted through person-to-person contact, and through contact with contaminated surfaces, emerging evidence shows the presence of airborne MRSA in hospital settings. It poses a new risk to patients and health care workers.
So, researchers from UC's division of environmental and industrial hygiene in the Department of Environmental and Public Health Sciences at the College of Medicine will conduct laboratory and field work at UC Medical Center.
If live MRSA is discovered in the air, researchers will recommend disinfecting the air and offer other recommendations to further enhance workplace safety.
Click here to read the UC News report on the grant and the research.
Featured image at top: Gloved hand holding Petri dish with bacteria growing. Photo/Provided.
Related Stories
Sugar overload killing hearts
November 10, 2025
Two in five people will be told they have diabetes during their lifetime. And people who have diabetes are twice as likely to develop heart disease. One of the deadliest dangers? Diabetic cardiomyopathy. But groundbreaking University of Cincinnati research hopes to stop and even reverse the damage before it’s too late.
Is going nuclear the solution to Ohio’s energy costs?
November 10, 2025
The Ohio Capital Journal recently reported that as energy prices continue to climb, economists are weighing the benefits of going nuclear to curb costs. The publication dove into a Scioto Analysis survey of 18 economists to weigh the pros and cons of nuclear energy. One economist featured was Iryna Topolyan, PhD, professor of economics at the Carl H. Lindner College of Business.
App turns smartwatch into detector of structural heart disease
November 10, 2025
An app that uses an AI model to read a single-lead ECG from a smartwatch can detect structural heart disease, researchers reported at the 2025 Scientific Sessions of the American Heart Association. Although the technology requires further validation, researchers said it could help improve the identification of patients with heart failure, valvular conditions and left ventricular hypertrophy before they become symptomatic, which could improve the prognosis for people with these conditions.
